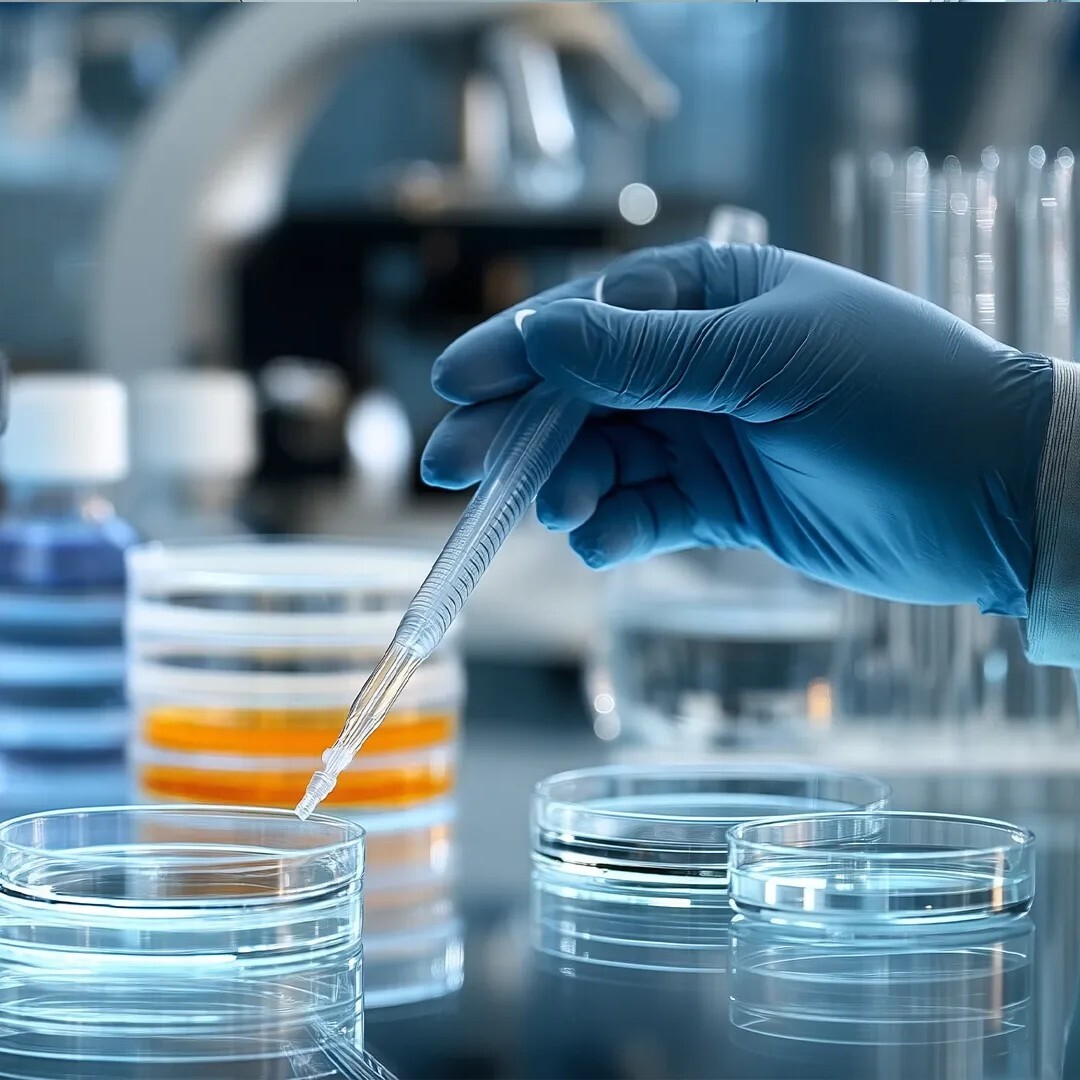
4flow-life-sciences-square

- April 14-16, 2026
- Austria Center Vienna
- Vienna, Austria
The 4flow team will be onsite at LogiPharma 2026, the leading event for pharmaceutical supply chain leaders.
Book a meeting or stop by booth #49 to speak to 4flow’s experts about supply chain orchestration.
4flow helps you orchestrate your supply chain, from planning to operations, and achieve measurable results:
- End-to-end visibility and real-time data through control tower and APS integration
- Agile, reliable planning with AI-driven demand prediction and scenario planning
- Lower cost-to-serve while ensuring product integrity with smarter network design and transportation strategies
- Faster launch and compliance processes thanks to automation, audit-readiness and cross-functional orchestration
Masterclass with 4flow, Aspen and Octapharma
From visibility to orchestration: how Aspen creates sustainable impact with their supply chain transformation
Tuesday, April 14
12 - 12:50 PM
Speakers



Also of interest

Testimonials
"As a partner, we’ve seen firsthand the value of 4PL expertise in enhancing supply chain efficiency and enabling us to focus on our core mission of delivering life-saving treatments to patients worldwide."
Deniz Sahin
Head of Global Logistics Operations, UCB
“What we valued most when collaborating with 4flow were the detailed data insights that ensured the information was accurate. Using such insights, we were able to create realistic targets through each phase of the project.”
Erin Templeton
Senior Program Manager, Business Process Excellence, BD Biosciences
4flow’s business lines
- Managed services
- Consulting
- Software
Supply chain managed services
Supply chain managed services
4flow management is an optimization specialist for logistics networks and global supply chains. Our services enable significant reductions in transportation and management costs while increasing service levels and performance. As a neutral, non-asset-based provider, we find the best solution for each customer in any given situation at optimal cost. Businesses quickly benefit from our collaboration and can concentrate on their core competencies.
In addition to reduced costs, customers achieve the greatest possible transparency in their networks and more flexibility in their supply chains.
Supply chain consulting
Supply chain consulting
4flow’s supply chain consulting offers one-stop management consulting, concept development, and implementation support for logistics and supply chain management. Typical results include cost reduction, more efficient processes, and improved service. Because every project is unique, custom-made solutions are part of what we do.
We establish a close partnership with the customer’s team and consider processes end to end to ensure a sustainable solution.
Supply chain software
Supply chain software
The planning approach of 4flow’s supply chain software spans from optimization of network structures for the long term to optimization of transportation capacities for the short term. Our software allows users to plan and manage inbound and outbound networks as well as transportation between plants. Material and empties flows can be evaluated. Modules can be applied individually or as a whole, using a common database. The result is efficient, sustainable cost reduction for our customers.
Automotive customers
Related topics



Meet us at #ALSCGLOBAL
Location
SPARK | Frankfurt, Germany
Date and time
Thursday, May 15, 2025 | All-day event